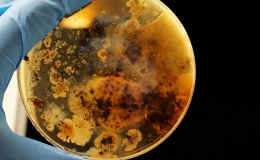

Những bí ẩn tự nhiên chưa thể lý giải
Các nhà khoa học vẫn chưa tìm ra nguyên nhân dẫn tới sự hình thành của nhiều hiện tượng tự nhiên hiếm gặp như ngọn lửa vĩnh cửu hoặc vòng tròn thần tiên.
7 tháng trước 2,068 lượt xem

Công ty Mỹ tuyên bố khai thác helium-3 trên Mặt Trăng
Công ty khởi nghiệp tư nhân Interlune ở Seattle tìm ra cách khai thác helium-3 từ đất Mặt Trăng và ký hợp đồng bán loại khí này hàng chục triệu USD/kg vào năm 2029.
7 tháng trước 2,191 lượt xem

Tên lửa Starship chuẩn bị cho chuyến bay thử thứ 9
SpaceX đang gấp rút kiểm tra những điều chỉnh ở tên lửa Starship sau thất bại liên tiếp từ hai lần phóng gần đây và dự kiến bay thử chuyến thứ 9 tuần sau.
7 tháng trước 1,526 lượt xem

Bể chứa nước dưới lòng đất lớn nhất thế giới
Kênh thoát nước ngầm dưới thành phố Kasukabe, có thể chứa lượng nước lũ tương đương 268 bể bơi Olympic được mệnh danh bể chứa "lớn nhất thế giới".
7 tháng trước 2,343 lượt xem

VnExpress tổ chức giải thưởng AI Awards 2025
Giải thưởng AI Awards 2025 được VnExpress khởi động từ cuối tháng 5 nhằm tìm ra các sản phẩm, cá nhân và doanh nghiệp AI tiêu biểu tại Việt Nam.
7 tháng trước 2,051 lượt xem
Phát hiện kháng sinh mới có thể chống lại siêu vi khuẩn
Các nhà khoa học phát hiện saarvienin A, loại kháng sinh glycopeptide hoàn toàn mới từ một chủng vi khuẩn khác thường ở Trung Quốc.
7 tháng trước
1,353 lượt xem
Đề tài về chip RISC-V đoạt giải nhất thiết kế vi mạch TP HCM
Đề tài vi điều khiển RISC-V tiết kiệm năng lượng của Nguyễn Đoàn Hoàng Phúc vượt qua 67 bài dự thi đoạt giải nhất tại cuộc thi thiết kế vi mạch tại TP...
7 tháng trước
1,485 lượt xem
Thái Bình: Phát triển khoa học công nghệ, đổi mới sáng tạo và chuyển đổi số
Khoa học công nghệ (KHCN), đổi mới sáng tạo (ĐMST) và chuyển đổi số (CĐS) là động lực, nền tảng vững chắc thúc đẩy phát triển kinh tế - xã hội. Tại Thái...
7 tháng trước
1,723 lượt xem
Nhà khoa học đặt niềm tin vào cơ hội mới
Những người làm khoa học và phát triển công nghệ cho rằng môi trường, thể chế đang dần cải thiện, mở ra nhiều cơ hội, nhất là sau khi có Nghị quyết...
7 tháng trước
1,845 lượt xem
Những sản phẩm nổi bật tại Ngày hội Khoa học Công nghệ 2025
Mô hình vệ tinh, robot chiến trường, robot cứu hoả, giải pháp "xanh" thu hút sự quan tâm tại Ngày hội Khoa học Công nghệ 2025.
7 tháng trước
2,026 lượt xem
Xác định vai trò then chốt của khoa học, công nghệ, đổi mới sáng tạo và chuyển đổi số trước yêu cầu phát triển đất nước
Sáng ngày 17/5, Thủ tướng Chính phủ Phạm Minh Chính, Trưởng ban Chỉ đạo của Chính phủ về phát triển khoa học, công nghệ, đổi mới sáng tạo, chuyển đổi số...
7 tháng trước
13,824 lượt xem
Hệ thống drone kiểm tra thần tốc đường dây điện
Drone tự động giúp giảm thời gian kiểm tra 5 tháp truyền tải điện từ hơn một ngày xuống chỉ còn khoảng nửa tiếng.
7 tháng trước
1,181 lượt xem
'Biến trí tuệ thành tài sản để đưa Việt Nam phát triển'
Bộ trưởng Khoa học và Công nghệ Nguyễn Mạnh Hùng cho rằng đất nước phát triển dựa phần lớn vào tài sản trí tuệ nên cần thúc đẩy tại Việt Nam.
7 tháng trước
1,528 lượt xem
Chiều nay diễn ra Ngày hội Khoa học và Công nghệ Việt Nam
Ngày hội Khoa học Công nghệ Việt Nam ghi nhận những đóng góp cho khoa học, truyền cảm hứng nghiên cứu, chế tạo. Dịp này, VnExpress trao giải Sáng kiến...
7 tháng trước
2,420 lượt xem
Robot tự hành hai chân nhỏ nhất thế giới
Robot Zippy của Đại học Carnegie Mellon có chiều cao chưa đến 4 cm, có thể tự khởi động, đi bộ, nhảy, rẽ ngoặt và leo bậc thang.
7 tháng trước
1,009 lượt xem